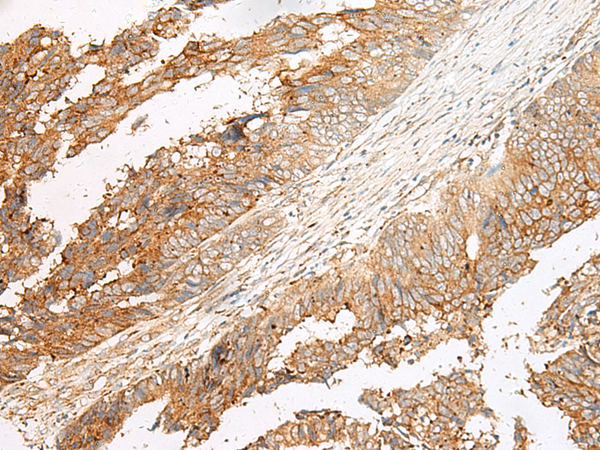

|
Background: |
Dual specificity receptor for uracil nucleotides and cysteinyl leukotrienes (CysLTs). Signals through G(i) and inhibition of adenylyl cyclase. May mediate brain damage by nucleotides and CysLTs following ischemia. |
|
Applications: |
ELISA, IHC |
|
Name of antibody: |
GPR17 |
|
Immunogen: |
Synthetic peptide of human GPR17 |
|
Full name: |
G protein-coupled receptor 17 |
|
SwissProt: |
Q13304 |
|
ELISA Recommended dilution: |
5000-10000 |
|
IHC positive control: |
Human colorectal cancer |
|
IHC Recommend dilution: |
30-150 |
購物車
購物車 幫助
幫助
 021-54845833/15800441009
021-54845833/15800441009
